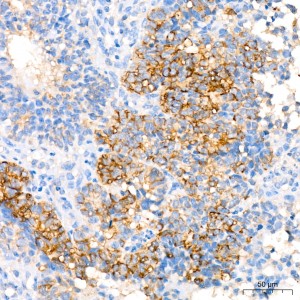
KO-Validated βIII-Tubulin Rabbit mAb (20 μl)

KO-Validated βIII-Tubulin Rabbit mAb (20 μl)
| Reactivity: | Human, Mouse |
| Applications: | WB, IHC, IF/IC, IP, ELISA |
| Host Species: | Rabbit |
| Isotype: | IgG |
| Clonality: | Monoclonal antibody |
| Gene Name: | tubulin beta 3 class III |
| Gene Symbol: | TUBB3 |
| Synonyms: | CDCBM; FEOM3; TUBB4; CDCBM1; CFEOM3; beta-4; CFEOM3A; in |
| Gene ID: | 10381 |
| UniProt ID: | Q13509 |
| Clone ID: | 9H6W10 |
| Immunogen: | A synthetic peptide corresponding to a sequence within amino acids 351-450 of βIII-Tubulin (NP_006077.2). |
| Dilution: | WB 1:3000-1:20000; IHC 1:50-1:200; IF/IC 1:50-1:200 |
| Purification Method: | Affinity purification |
| Concentration: | 1.59 mg/ml |
| Buffer: | PBS with 0.05% proclin300, 0.05% BSA, 50% glycerol, pH7.3. |
| Storage: | Store at -20°C. Avoid freeze / thaw cycles. |
| Documents: | Manual-TUBB3 monoclonal antibody |
Background
This gene encodes a class III member of the beta tubulin protein family. Beta tubulins are one of two core protein families (alpha and beta tubulins) that heterodimerize and assemble to form microtubules. This protein is primarily expressed in neurons and may be involved in neurogenesis and axon guidance and maintenance. Mutations in this gene are the cause of congenital fibrosis of the extraocular muscles type 3. Alternate splicing results in multiple transcript variants. A pseudogene of this gene is found on chromosome 6.
Images
 | Western blot analysis of lysates from wild type (WT) and βIII-Tubulin knockout (KO) HeLa cells using [KO Validated] βIII-Tubulin Rabbit mAb (A24067) at 1:3000 dilution. Secondary antibody: HRP-conjugated Goat anti-Rabbit IgG (H+L) (AS014) at 1:10000 dilution. Lysates/proteins: 25 μg per lane. Blocking buffer: 3% nonfat dry milk in TBST. Detection: ECL Basic Kit (RM00020). Exposure time:20s. |
 | Immunohistochemistry analysis of paraffin-embedded Human endometrium cancer tissue using [KO Validated] βIII-Tubulin Rabbit mAb (A24067) at a dilution of 1:200 (40x lens). High pressure antigen retrieval performed with 0.01M Citrate Bufferr (pH 6.0) prior to IHC staining. |
 | Confocal imaging of paraffin-embedded mouse brain using [KO Validated] βIII-Tubulin Rabbit mAb (A24067,dilution 1:200) followed by a further incubation with Cy3 Goat Anti-Rabbit IgG (H+L) (AS007,dilution 1:500)(Red).DAPI was used for nuclear staining (Blue). Objective: 40x.Perform high pressure antigen retrieval with 0.01 M citrate buffer (pH 6.0) prior to IF staining. |
 | Immunoprecipitation of βIII-Tubulin in 300 µg extracts from HeLa cells using 3 µg [KO Validated] βIII-Tubulin Rabbit mAb (A24067). Western blot analysis was performed using [KO Validated] βIII-Tubulin Rabbit mAb (A24067) at 1:3000 dilution. |
You may also be interested in: